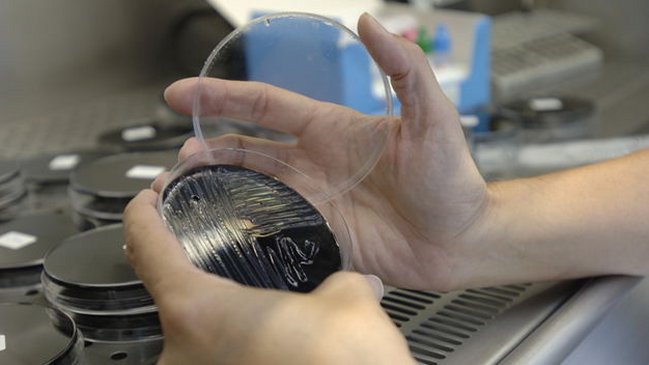
Qué es la legionelosis, el brote que alerta a Nueva York

En cuatro semanas desde que se diagnosticó el primer caso, 12 personas han muerto y al menos 113 resultaron infectadas de legionela en El Bronx, uno de los vecindarios más grandes y poblados de la ciudad de Nueva York, en Estados Unidos.
Las autoridades creen que el brote se desató en los tanques de enfriamiento en varios edificios del sur de El Bronx.
Al menos 12 tanques han dado positivo con la bacteria y ya han sido descontaminados. 53 de las personas enfermas recibieron tratamiento y ya fueron dada de alta.
Según informaron autoridades sanitarias del estado de Nueva York, cada año se presentan entre 200 y 800 casos de legionela, pero un brote generalizado de esta magnitud, con tantas víctimas en tan poco tiempo, no se había visto recientemente.
BBC Mundo le explica qué es la legionela y cómo tratarla.
¿Qué es la enfermedad de la legionela?
La legionela, legionelosis o enfermedad del legionario, es una infección pulmonar potencialmente mortal, causada por la bacteria Legionella.
La bacteria encuentra un terreno óptimo para desarrollarse en ambientes húmedos, con material orgánico y muchas veces con altas temperaturas.
La enfermedad no se contagia directamente de persona a persona, sino que se produce por la inhalación de pequeñas gotas de agua o vapores, contaminados con la bacteria.
El nombre "legionela" o "enfermedad del legionario" se deriva de un grupo de veteranos llamado "Legión Americana" que asistía a una convención en el hotel de Filadelfia en el que fue identificado el primer caso, en 1976.
¿Cuáles son las causas?
La bacteria de la legionela se encuentra comúnmente en las fuentes de agua como ríos y lagos, que a veces encuentran su camino a los sistemas de abastecimiento de aguas artificiales.
Las más grandes fuentes de contagio son edificios, hoteles, hospitales que tengan humidificadores, aires acondicionados, torres de refrigeración, o cualquier reserva de agua.
Estos lugares son más vulnerables a la contaminación porque tienen sistemas de abastecimiento de agua más grandes, más complejos y las bacterias se pueden propagar rápidamente.
Las torres de refrigeración emiten un vapor que puede portar la bacteria e infectar a la gente dentro de los edificios.
¿Cuáles son los síntomas de la enfermedad?
Los síntomas iniciales incluyen fiebre alta y dolor muscular.
Una vez que las bacterias comienzan a infectar los pulmones, los pacientes también pueden desarrollar una tos persistente.
Otros síntomas incluyen dificultad para respirar, dolor en el pecho y en ocasiones, vómitos y diarrea.
Las autoridades han dicho que es "el peor brote en la historia de la ciudad de Nueva York". (Foto: EFE)
¿Cuáles son los factores del brote en el Bronx?
El brote se originó a principio de julio en unas torres de enfriamiento del sector, que es una zona densamente poblada.
El Hospital Lincoln Medical and Mental Health Center, el Hotel Opera House, el centro comerncial Concourse Plaza, y edifcios de oficinas de Verizon y Streamline Plastics Company, son cinco de las edificaciones de El Bronx que hasta ahora han dado positivas con la bacterias.
Las torres ya han sido descontaminadas.
Las autoridades se encuentran realizando pruebas en otras 17 edificaciones de la zona.
39 edificios de la zona afectada del sur del Bronx tienen torres de refrigeración del tipo asociado a este brote, informaron las autoridades.
Los funcionarios a cargo han dicho que es "el peor brote en la historia de la ciudad de Nueva York".
El alcalde de Nueva York, Bill de Blasio, dijo que el agua es potable y que el brote ha sido "contenido".
Por su parte, el gobernador del estado, Andrew Cuomo, anunció que serán ofrecidas pruebas de legionela gratis en la ciudad.
Aunque la mayoría de los casos de enfermos afectados están vinculados geográficamente al sur de El Bronx, al noreste de la ciudad de Nueva York, una mujer -no contada entre las 12 víctimas- murió esta semana en Michigan, otro estado del país.
¿Quién tiene mayor riesgo de contraer la enfermedad?
La enfermedad del legionario es tres veces más común en hombres que en mujeres, y en su mayoría afecta a las personas mayores de 50.
Todo el mundo es potencialmente vulnerable a la enfermedad, pero los que pueden experimentar una forma más grave de la infección son los ancianos, fumadores, enfermos de diabetes, personas que padezcan enfermedades renales o cáncer.
Cifras de la organización Legionella.org indican que en EE.UU. entre 56.000 y 113.000 personas contraen la legionela cada año.
El 10 por ciento de las personas que contraen la enfermedad mueren por complicaciones derivadas de la infección.
¿Cómo tratar la legionela?
La legionela se trata con antibióticos por vía intravenosa.
Los expertos en salud dicen que la clave para recuperarse de la legionela es recibir tratamiento con el antibiótico adecuado, para el tipo específico de legionela, tan pronto como sea posible.